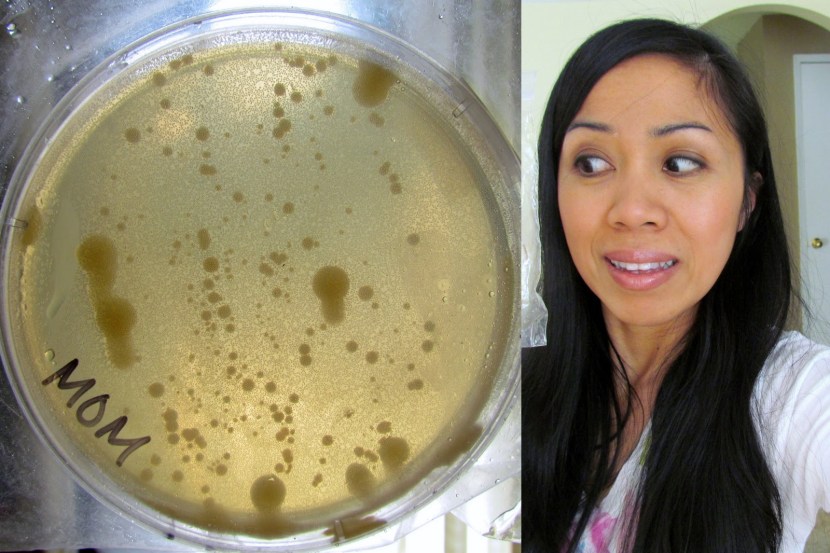

Belly Button Club Flow (89 photos)

Belly Batton Nevel play

Irina Mayer Ciri Cyberpank

Belly Button Girl

BellyCool Navel

Belly Batton Nevel play

Women with a convex navel naked

Bellybutton young girls Art

Riley Vuolkel Beach

Intense Pregnant Popped Belly Button Orgasm

Equestria Girls Rarity Belly Button

Sanset Shimmer and Rariti

The frame for the playlist

Bellybutton Babes Sex Board Fetish

Anime Girl Belly Button

Female Navel

Giant Tickle Navel

Belly Punch

Anime Girl Belly Button

El Jack in a swimsuit

Manga girl with big breasts

Rindo Rindo

Anime Navel Lick

BellyCool Navel

Heartbeat girl

Tickling girls for boobs

Massage chair JB-K002

Expansion Bubs

Malika with an open belly

Rihanna Belly

Piercing jeans jacket

Belly Batton Nevel play

Liam Eiken torso
Belly Batton Nevel play

Melissa Benoist

Belly Button Kissing

A girl's deep navel

BellyCool Navel

Barista Expansion

Bellybutton young girls

Maura Higgins drain

Equestria Gerls Reinbou Dash in a swimsuit

Katerina Prost

Equestri Gerles in underwear

M9 Bayonet Standoff 2

Is it possible to wash with piercing

Outie Belly Indian

Crayon in the Belly

Belly Punch

Anime Belly Button Girl

The navel of Japanese girls

White stars on a transparent background

Panda Gerl 1000x in 2022

Dalmatians street 101 Dee Dee

Follow the footage to subscribe

Anime belly

Galaxi knife in the stomach

Belly Button Low Rise

Belly girl

Vinyl Scretch SFM 18+TwistedScarlett60

Images for a photo shoot for a group of girls in swimsuits

Anime Tickling Belly

Flowing liquid

Belly Button Beauties Manga

Horizontal puncture of the navel

Eropony Celestia

Belly Showing Stretching

Sanset Shimmer Forgotten Friendship

Navel Love Video

Florence Pugh Tongue

Girl with piercing in her navel

Belly Heling

Rarity Girl Equestria on a Yacht

Acupuncture of the stomach

The navel of the manga anime

Belly Batton Nevel Paley Japanese

Anya Dobrydneva Belly Button

Neon figures without a background

Girl on Porsche Kayen











0
Share on social networks:
Commentary:








